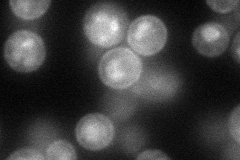
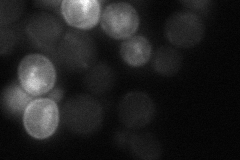
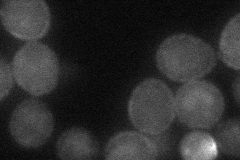

View description
Dicarboxylic amino acid permease, mediates high-affinity and high-capacity transport of L-glutamate and L-aspartate; also a transporter for Gln, Asn, Ser, Ala, and Gly
Localization:
Intensity:
Fold change:
Significance:
-
C’ GFP library in SD

cell periphery219.91 -
N' NOP1pr-GFP in SD
cell periphery,vacuole62.4169 -
N' TEF2pr-mCherry in SD

cell periphery,vacuole67.5994 -
N' NATIVEpr-GFP in SD
cytosol27.3568 -
N' TEF2pr-VC and Cyto-VN in SD
cell periphery36.37 -
C’ GFP library in SD+DTT

vacuole19.950.09Yes -
C’ GFP library in SD+H2O2

punctateN/AN/ANo -
C’ GFP library in Starvation Media

vacuole, cell peripheryN/AN/AYes -
C’ GFP library on the background of Pup2-DaMP

cell periphery -
C’ GFP library on the background of CCT mutant

cell periphery241.9241.10008No
